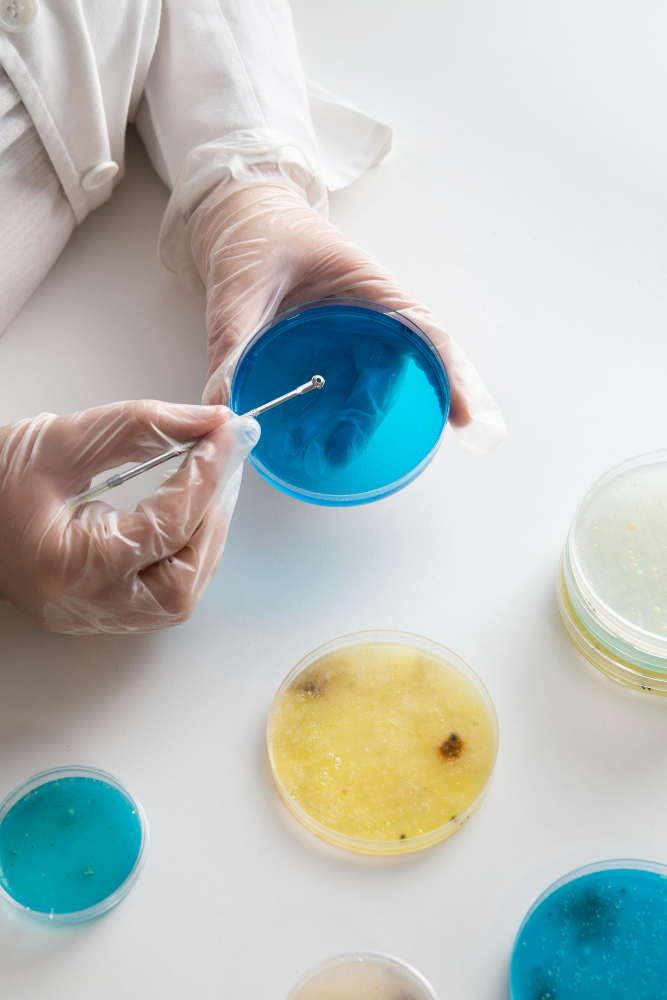

A Semen Test, or Semen Analysis, checks a man’s sperm count, movement, and shape.

Detects infections like HIV, chlamydia, gonorrhoea, syphilis, herpes, HPV, and hepatitis.

A CBC (Complete Blood Count) test checks overall health and helps detect conditions like infections and anemia.

A Cholesterol Test (Lipid Profile) measures levels of fats in your blood, helping assess your risk of heart disease, stroke etc.

A Thyroid Test measures hormone levels in your blood to assess thyroid gland function, which regulates metabolism and energy several other.

NIPT (Non-Invasive Prenatal Testing) is a safe blood test during pregnancy that analyzes fetal DNA in the mother’s blood to screen for genetic conditions.

A DNA test is a lab test that examines your genetic code to identify relationships, detect disorders,

A Beta hCG test is a blood test that measures hCG hormone levels.

A Liver Function Test (LFT) checks liver health by measuring enzymes, proteins, and bilirubin levels.

Vitamin tests measure blood levels of essential vitamins to detect deficiencies. They help diagnose causes of fatigue, weakness, or bone issues and guide proper nutritional supplementation.

An HIV test checks for the presence of the Human Immunodeficiency Virus in the body. Early detection allows prompt treatment and helps prevent spreading the virus to others.

A Hormone Test checks hormone levels in blood, urine, or saliva. It helps evaluate issues related to growth, metabolism, fertility, mood changes, or other hormonal imbalances.

Cancer screening blood tests detect early signs of cancer by measuring specific markers or substances in the blood that may indicate the presence or risk of certain cancers.

Cancer screening blood tests detect early signs of specific cancers common in women, helping with early diagnosis, better treatment planning,

An Antenatal Panel Test includes blood and urine tests during pregnancy to check the health of mother and baby, identify risks, and ensure a healthy, safe pregnancy.

This Fitness Profiling is a mandatory medical screening to ensure foreign workers are healthy and free from infectious or chronic diseases before entering Bahrain for employment.

Shipping crew pre-medicals are mandatory health tests done before duty onboard. They ensure crew fitness, absence of contagious diseases, and readiness for safe service at sea.
Our 24/7 healthcare service ensures that you and your family receive the care you need, no matter the time. Whether it’s emergency care, regular check-ups, or specialist consultations, we’re here round-the-clock to provide reliable, accessible, and high-quality health services whenever you need them.
The MRI was smoother than I expected. The staff made everything easy, and the results helped my doctor make an accurate diagnosis.

The mammogram was quick, and the staff was very helpful. I felt confident in the results and the care I received.

The CT scan was efficient and easy. The staff was friendly, and the process was fast. I received clear results in no time.

My Dexa scan was quick and simple. The staff made me feel comfortable, and I got the detailed results I needed for my bone health.